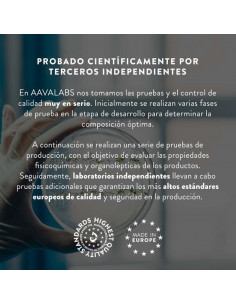
Complemento Alimenticio... 2

Su carrito
No hay más artículos en su carrito.
Artículos de bienestar y relajación
Bolsa de Agua Caliente Estrellas (26 X 20 cm) 119604
BigBuy Wellness
S1125166
7,60 €